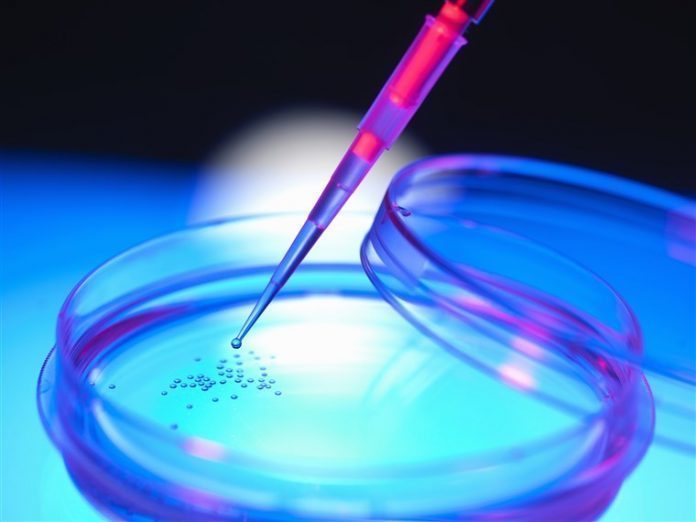

En el programa de hoy, la Dra. Carrasco, directora médico de la Clínica de Medicina Estética Borne 15, nos explica en que consiste Cellular Matrix.
El concentrado de plaquetas (A-PRP) del paciente preparado con Cellular Matrix proporciona un depósito autólogo de factores de crecimiento de la sangre del paciente.
Las plaquetas son factores clave en los mecanismos de reparación de tejidos duros y blandos 1. Proporcionan factores de crecimiento esenciales, como FGF, PDGF, TGF-ß, EGF, VEGF, IGF, que están implicados en la migración, diferenciación y proliferación de células madre. Además, las plaquetas también estimulan los fibroblastos y las células endoteliales para inducir nueva deposición de matriz extracelular y neovascularización, respectivamente.
El plasma contiene muchos factores esenciales para la supervivencia celular, que incluyen nutrientes, vitaminas, hormonas, electrolitos, factores de crecimiento (como IGF y HGF) y proteínas. Entre las proteínas del plasma, las moléculas vitales para el proceso de coagulación y para la formación del polímero de fibrina servirán como un andamio para la migración celular y la generación de nuevos tejidos.
- Se ha comprobado su eficacia en la curación de tejidos blandos y duros, con acciones clave sobre migración celular, proliferación y diferenciación.
- Los crecientes datos probatorios que sustentan el tratamiento del mecanismo de acción de OA comprenden actividad antiinflamatoria y activación de cascadas de señalización celular.
- Su rol es clave en la nueva síntesis de matriz para la regeneración tisular.
El ácido hialurónico (HA) es un componente principal del líquido sinovial que proporciona elasticidad y contribuye a la homeostasis articular. Este componente es necesario para obtener un efecto lifting gracias al relleno de arrugas de la piel.
- 25 años de experiencia clínica demuestran un alivio del dolor y una mejoría funcional que se prolonga de 6 a 12 meses.
- Su rol es importante en la viscosuplementación y el alivio del dolor en OA.
- Una red de cadenas HA constituye una matriz ideal para las células.
Como el ácido hialurónico ya se utilizaba anteriormente, la Dra. Carrasco nos explica cuál es la novedad del Cellular Matrix. Es un nuevo método que combina sinérgicamente los efectos clínicos complementarios del plasma rico A-PRP y HA para proporcionar un beneficio adicional a los pacientes y fomentar el rejuvenecimiento.
La Dra. Carrasco explica que, tanto el HA como el A-PRP del paciente preparado con Cellular Matrix, tiene excelentes perfiles de seguridad en la práctica clínica. Además también nos comenta que este método también se utiliza para tratamientos de traumatología.
Clínica de Medicina Estética Borne 15
Pida hora sin compromiso.
971 227 463 – 648 220 839
Passeig d’es Born nº15 – 1ºC, Palma
[email protected]
www.borne15.com
Escucha PODCAST de la sección de medicina estética que dirige la doctora Marisol Carrasco en IB Magazine.